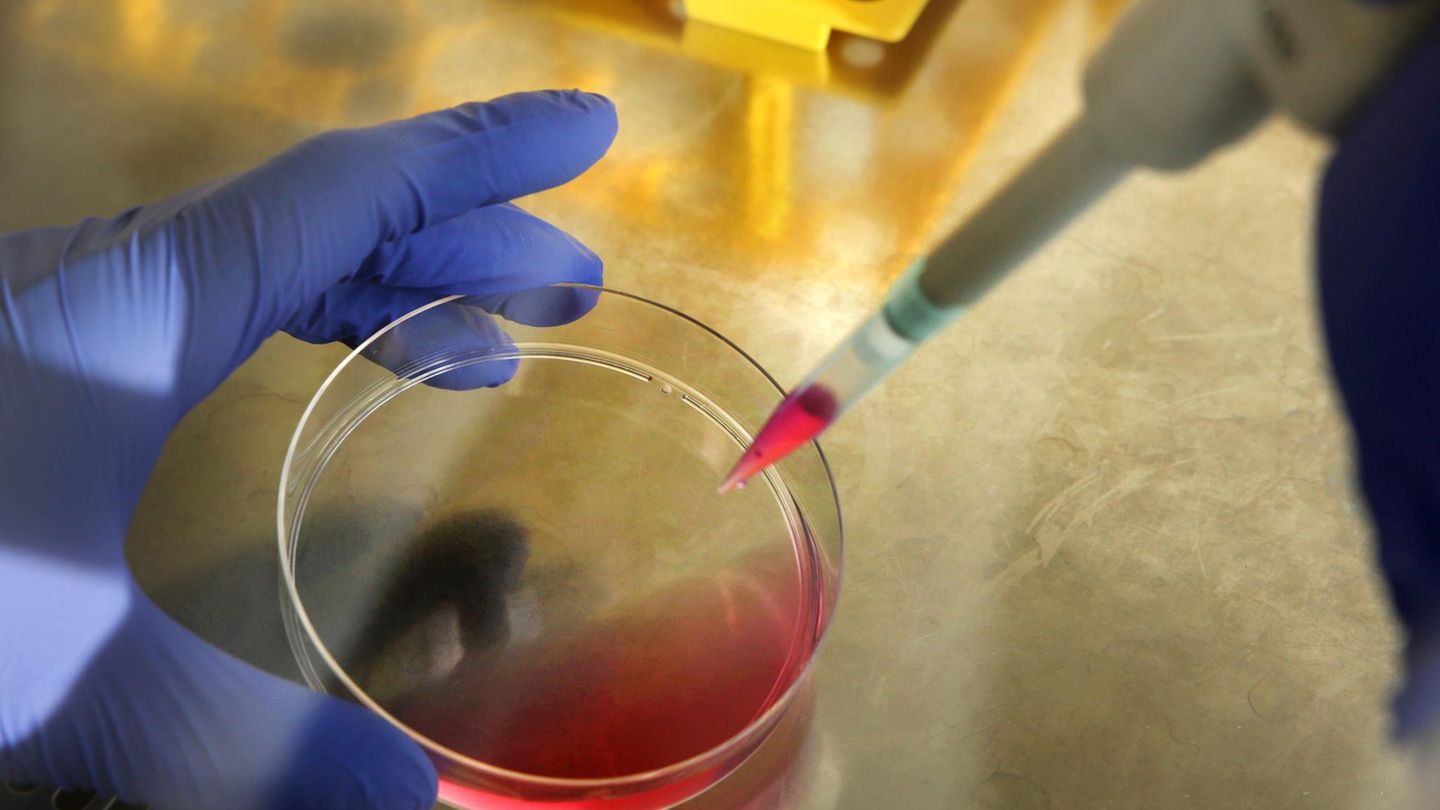

Sie kamen aus vielen Teilen der Welt: aus dem Nahen Osten, aus Russland, Australien und auch aus Deutschland. Eltern schwerkranker Kinder, die ihre ganze Hoffnung auf den deutschen Arzt Christoph Klein setzten. Eine Gentherapie sollte ihre kleinen Jungen im besten Fall für immer heilen. Dass die Kinder an einer experimentellen Studie mit einer noch kaum erprobten Methode teilnehmen sollten, schreckte sie nicht ab. Die einzige Alternative war eine Stammzellentransplantation - und auch diese ist nicht immer erfolgreich und hat erhebliche Nebenwirkungen.
Der renommierte Wissenschaftler Klein behandelte ab 2006 in seiner Zeit an der Medizinischen Hochschule Hannover zehn Jungen mit dem seltenen lebensbedrohlichen Wiskott-Aldrich-Syndrom (WAS). Am Ende erkrankten acht von ihnen an Leukämie, bis heute sind drei gestorben.
Arzt Christoph Klein gerät unter Druck
Angesichts des desaströsen Verlaufs gerät der Arzt, heute einer der Direktoren des Dr. von Haunerschen Kinderspitals in München, in die Kritik. Nach einem Bericht im Magazin der "Süddeutschen Zeitung" kündigt die Uniklinik München, zu der das Kinderspital gehört, eine Untersuchung an.
Während in Hannover noch eine Prüfung läuft, hat die Kommission zur "Selbstkontrolle in der Wissenschaft" Klein nun rundweg entlastet. Die Kommission ist eine Einrichtung der medizinischen Fakultät der Ludwig-Maximilians-Universität (LMU) München. Die Untersuchung habe keinen "Anhalt für wissenschaftliches, ärztliches, rechtliches oder ethisches Fehlverhalten" Kleins ergeben, hieß es am Montag.
Verzweifelte Eltern bitten um Hilfe
"Ich freue mich über die Rehabilitierung unserer ärztlichen und wissenschaftlichen Arbeit", teilte Klein auf Anfrage mit. Er sieht sich ungerechtfertigten Verdächtigungen, Mutmaßungen und Verurteilungen seitens der Zeitung ausgesetzt.
Nur Jungen sind von dem Gendefekt betroffen, der WAS auslöst. Sie leiden an Blutungen, manche sterben unbehandelt nach wenigen Jahren, die meisten erreichen das Erwachsenenalter nicht.
Als Kleins neuer Therapieansatz bekannt wird, wenden sich Väter und Mütter aus aller Welt an ihn. Die Briefe der verzweifelten Eltern seien anrührend gewesen, berichtet der Leiter der Kommission, Udo Löhrs. Manche seien spontan gekommen "und haben um Hilfe gebeten". "Aus damaliger Sicht war es das Prinzip Hoffnung", sagt auch Karl-Walter Jauch, Ärztlicher Direktor des Klinikums der LMU.
Die Kinder schienen geheilt zu sein
Nur bei einem Jungen schlug das Verfahren gar nicht an. Bei neun Kindern wurde es komplett durchgeführt. Mit seinem Wechsel nach München nahm Klein die Nachbetreuung der Kinder mit. Anfangs sah alles gut aus: Die Kinder schienen geheilt. Klein veröffentlichte seine Erfolge, er wurde vielfach ausgezeichnet. Doch in den Folgejahren erkrankten acht Jungen an Leukämie, drei starben. Die Studie, die ursprünglich 15 Kinder umfassen sollte, wurde nicht weitergeführt.
"Die Gentherapie ist erfolgreich gewesen, aber sie ist konterkariert worden durch die Komplikationen", sagt Löhrs. Bei der Methode werden sogenannte retrovirale Vektoren eingesetzt. Mit ihnen wurde eine synthetisch hergestellte, korrekte Gensequenz in die Stammzellen der Patienten gebracht. So sollte der Gendefekt, der WAS auslöst, aufgehoben werden. Doch dabei ging etwas schief - denn bei diesen Vektoren war nicht klar, wo genau das WAS-Gen eingebaut wurde. Als Klein die Studie startete, gab es noch keine zugelassene Alternative zu diesen Vektoren. "Heute wissen wir mehr, auch zum Teil durch diese Studie", sagt Löhrs.
Eine ähnliche Studie in Mailand war erfolgreich
Ob die Nebenwirkungen in dieser massiven Art hätten vorhersehbar sein können, bleibt Spekulation. Eine Studie in Frankreich bei Kleins Doktorvater Alain Fischer mit an einem anderen Gendefekt erkrankten Kindern war nach der Leukämieerkrankung dreier von vier behandelter Kinder gestoppt worden. In Mailand hingegen ging eine Studie mit denselben Vektoren gut.
Hätte länger nach geeigneten Stammzellenspendern gesucht werden sollen? "Das hängt vom Stand der Erkrankung ab, und das ist von außen nicht zu beurteilen", sagt der Berliner Rechtswissenschaftler Christian Pestalozza. "Wenn es Spender hätte geben können, hätte man danach suchen müssen."
Die Kommission kam zu dem Schluss, dass die Familien der Kinder ausreichend über die möglichen Nebenwirkungen und die Stammzell-Alternative aufgeklärt worden waren. Das hätten auch zwei unabhängige Gutachter, ein Medizinrechtler und ein Mediziner, so gesehen. Ihre Namen werden allerdings nicht veröffentlicht. "Warum erfahren wir nicht, wer die Gutachter sind", fragt Pestalozza.
Sind Gentherapien die Zukunft Medizin?
Die Debatte um die Gentherapie bei den WAS-Kindern wird nicht die letzte dieser Art sein. Neue gentechnische Methoden wecken neue Hoffnungen. Die Crispr/Cas-Technik etwa, die als eine Art Gen-Schere mit zuvor unerreichter Genauigkeit die DNA manipulieren kann. Bisher wird sie verwendet, um neue Pflanzen und Tiere mit besonderen Eigenschaften herzustellen.
Sie könnte aber vielleicht auch in der Therapie von Gendefekten zum Zuge kommen. "Was ich mir wünsche: Dass wir eine ganz intensive Diskussion, einen Diskurs haben werden unter Einbeziehung der Öffentlichkeit", sagt Löhrs. Denn Tierversuche können nicht alle Risiken zeigen - manche treten erst zutage, wenn die ersten Patienten behandelt werden. Mit womöglich tödlichem Risiko.